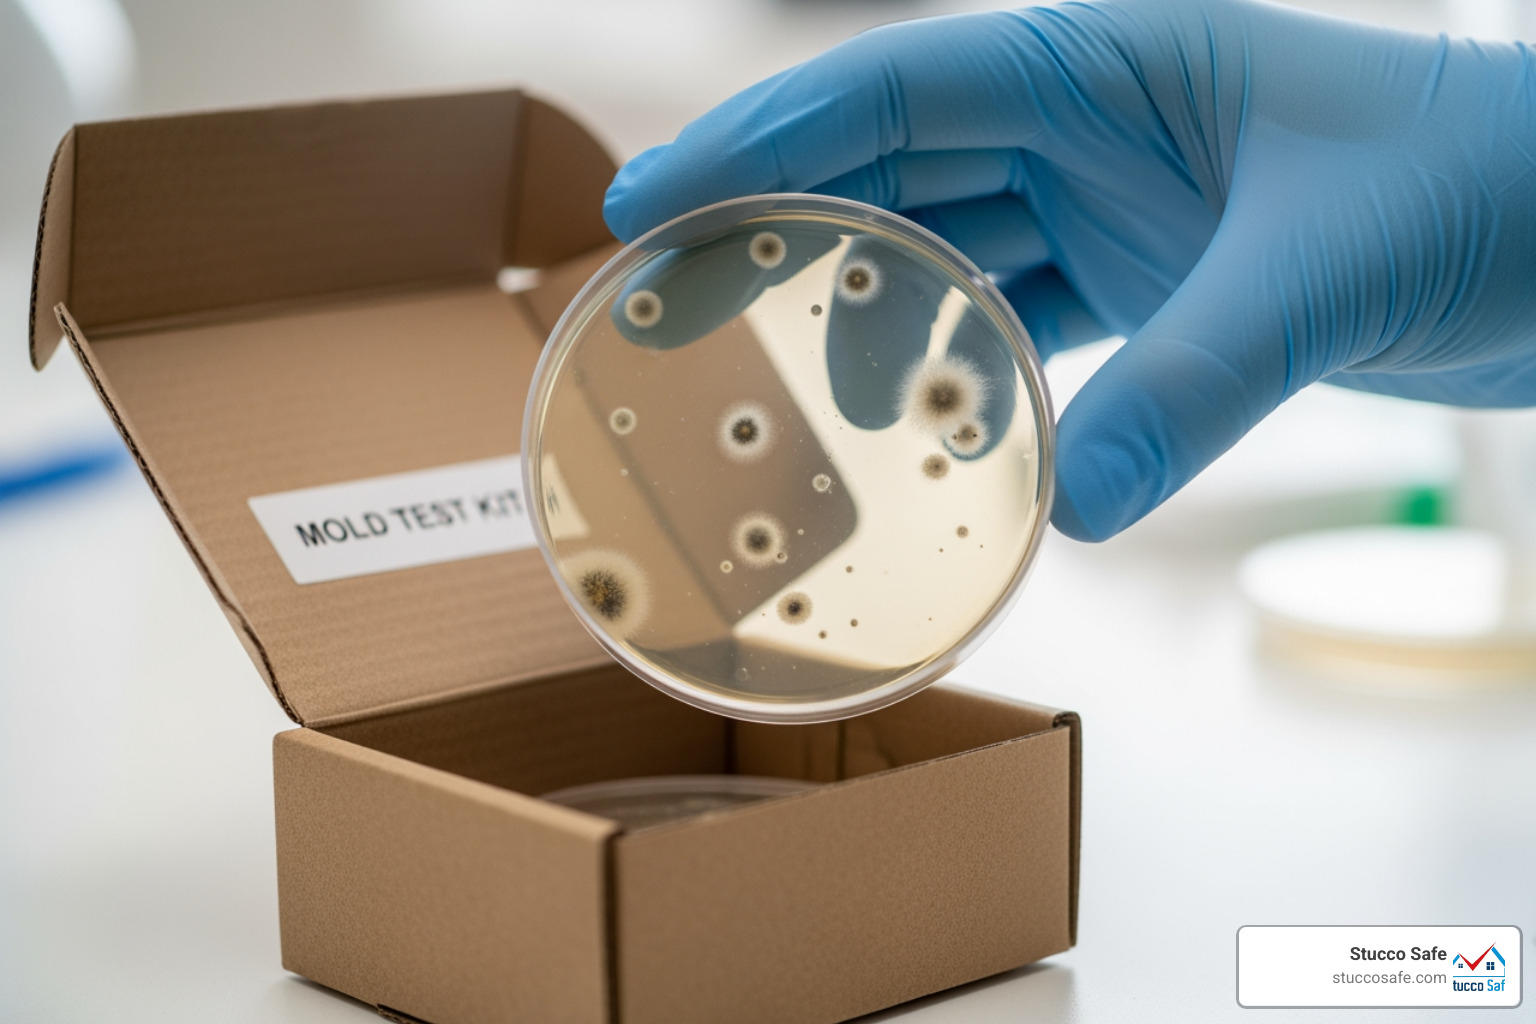
mold test kit petri dish being placed in a shipping box - do home mold test kits work mold test kit petri dish being placed in a shipping box - do home mold test kits work

The DIY Mold Test Dilemma: Are You Really Getting Reliable Results?
The Allure and Reality of Quick Mold Testing
Do home mold test kits work? The short answer is no, not reliably. Here’s what you need to know:
- DIY kits use “settle plate” methods that don’t accurately measure airborne mold
- They can’t detect hidden mold behind walls, under carpets, or in HVAC systems
- They fail to distinguish between dead and living spores (both can be harmful)
- Consumer Reports rates them “Not Recommended” due to significant flaws
- Expert organizations like the CDC, EPA, and ACGIH advise against their use
- They don’t identify the moisture source—the real cause of your mold problem
When you spot suspicious spots on your bathroom ceiling or catch that musty smell in your basement, it’s tempting to grab a $10 test kit from the hardware store. The promise is simple: set out a petri dish for 48 hours, mail it to a lab, and get answers about what’s growing in your home.
But here’s the problem—these kits rarely deliver on that promise.
The American Conference of Governmental Industrial Hygienists explicitly advises against using the sampling methods employed by these home test kits. Consumer Reports tested several popular kits and found them so unreliable that they sent an unused test plate to one lab—it came back positive for mold. Every kit they tested earned a “Not Recommended” rating.
The fundamental issue goes deeper than just accuracy. These kits can’t tell you where the mold is growing, why it’s there, or what to do about it. They can’t see behind your walls or under your floors. They can’t detect the moisture intrusion that’s feeding the growth. And they certainly can’t distinguish between a few harmless spores (which exist in every home) and a serious contamination problem requiring immediate attention.
For homeowners like Helen in Southeastern Pennsylvania, this matters even more when dealing with stucco homes, where moisture intrusion often hides behind exterior walls—exactly where a DIY test will never find it. A false negative from a home test kit could leave you with a growing problem that damages your home’s structure and value.
I’m Gabe Kesslick, a BESI Level 2 Certified Building Envelope Forensic Inspector who has investigated moisture and mold issues since 2001, and I’ve seen countless homeowners misled by DIY test results when evaluating whether do home mold test kits work for their situation. The reality is that proper mold assessment requires understanding building science, moisture dynamics, and professional testing protocols that no $10 kit can provide.
Explore more about do home mold test kits work:
The Science of “Settling”: Why DIY Kits Are Fundamentally Flawed
The allure of a DIY mold test kit is its apparent simplicity: just open a petri dish, leave it exposed for a day or two, and let nature do the rest. This is known as the “settle plate” method, and it relies on gravity to collect airborne mold spores. While it sounds straightforward, this approach is fundamentally flawed and provides an inaccurate picture of your home’s actual mold situation.
Here’s the rub: mold spores vary significantly in size, shape, and, most importantly, weight. Heavier mold spores will fall out of the air more quickly and, therefore, are disproportionately represented in these gravity-based collection dishes. Lighter, often more problematic, spores might remain suspended in the air, never making it into your petri dish. It’s like trying to count all the fish in a pond by only scooping up the ones that float to the surface – you’re going to miss a lot!
These home-test kits rely entirely on ambient air currents in a room over a 24 to 48-hour period. This means the results are highly influenced by uncontrolled variables like open windows, fans, or even someone walking by. The American Conference of Governmental Industrial Hygienists (ACGIH), a leading authority in indoor environmental quality, explicitly advises against using this type of sample collection for meaningful air quality diagnostics. Their manual, “Bioaerosols: Assessment and Control,” highlights the severe limitations and advises against DIY sampling kits due to a lack of context, appropriate tools, and professional interpretation.
As experts in mold and moisture investigations, we understand that accurately measuring airborne particles requires much more than a simple petri dish. Professional mold assessments measure mold spores per cubic meter using controlled airflow through mechanical pumps, ensuring a representative sample of airborne particles. Relying on gravity alone means you’re operating under uncontrolled conditions, making it impossible to get a truly reliable reading. You can learn more about how we accurately identify mold in your home by visiting our guide on How to Test for Mold.
The Problem with Petri Dishes
Imagine you leave a banana on your kitchen counter for a week. What happens? Mold, right? That’s because mold spores are ubiquitous – they’re present in nearly every indoor and outdoor environment, including your home in Southeastern Pennsylvania, New Jersey, or Delaware. This natural presence of mold spores is precisely why petri dish mold tests are so misleading.
When you expose a petri dish containing a growth medium, it’s almost guaranteed to come back “positive” for mold. Even an unused test plate sent to a home mold lab by Consumer Reports came back positive! This isn’t because you have a severe mold problem; it’s simply because mold spores are everywhere, and the petri dish provides an ideal environment for them to grow.
This creates a significant problem: false positives. A “positive” result from a DIY kit doesn’t tell you if the mold levels are normal for your environment, if there’s an active infestation, or if it’s causing a problem. It lacks context. Professional assessments always include outdoor control samples to compare indoor mold levels to what’s naturally occurring outside. Without this crucial comparison, a petri dish simply confirms the obvious: mold exists. It’s like saying, “Yes, there’s air in your house!” – technically true, but utterly unhelpful for diagnosing a problem.
Inaccuracies from Lab to Mailbox
The journey of your DIY mold sample from your home to a laboratory is fraught with potential pitfalls that can further compromise the accuracy of your results. You’ve gone through the effort of setting out the dish, collecting the sample, and now you’re mailing it off. But what happens during transit?
Samples sent via DIY kits can be exposed to extreme temperatures, humidity, and improper handling. Imagine a delicate biological sample sitting in a hot mail truck in July in Phoenixville, PA, or freezing in a mailbox in Brick, NJ, in January. These conditions can easily damage or contaminate the sample, leading to false positives or negatives once it finally reaches the lab. By simply mailing your test samples, they can get damaged or contaminated on the way to the lab, leading to inaccurate or false results.
Furthermore, the laboratories associated with many DIY kits are rarely certified by recognized agencies such as the AIHA-LAP LLC (American Industrial Hygiene Association Laboratory Accreditation Programs). This lack of accreditation means there’s no guarantee of consistent quality control, proper analytical methods, or accurate reporting. You might receive a report with confusing data, or worse, misleading conclusions. These lab inaccuracies, combined with the issues of dead spore ignorance (which we’ll discuss next), make DIY kits a risky gamble. Consumer Reports, in their experiment, highlighted these significant flaws, leading them to advise against all home mold test kits. We want our clients in areas like Chester County and Gloucester Township to have reliable information, not just a fancy, but ultimately useless, report.
What DIY Mold Tests Can’t Tell You (And Why It Matters)
The biggest drawback of DIY mold test kits is not just what they do tell you, but what they fail to disclose. A superficial “positive” result can create unnecessary panic, while a “negative” can lull you into a false sense of security, allowing a serious mold problem to fester unseen.
These kits are fundamentally limited because they cannot detect hidden mold, identify the crucial moisture source, or distinguish between viable and non-viable spores. For homeowners across Southeastern PA, New Jersey, and Delaware, overlooking these critical factors can lead to significant health risks and costly structural damage down the line. Our Visual Mold Inspection Ultimate Guide digs into the comprehensive approach needed to truly understand a mold problem.
The Hidden Mold You Can’t See
Mold is a master of disguise. It doesn’t always grow in plain sight. DIY mold test kits only sample visible mold or airborne spores in open areas. They are completely blind to mold growing behind walls, under carpets, inside HVAC systems, or in the hidden recesses of basements and attics. These are common hiding spots for mold in homes, especially in areas prone to moisture intrusion like stucco homes in West Chester, PA.
Think about it: if mold is growing behind your drywall in Edison, NJ, due to a leaky pipe, a petri dish sitting on your kitchen counter isn’t going to pick up those spores in meaningful concentrations. The levels of spores analyzed by these labs are not accurate, and they certainly cannot detect hidden mold, preventing the homeowner from properly assessing the situation. A significant portion of mold problems we encounter in places like Cherry Hill, NJ, or Phoenixville, PA, are initially hidden, often only revealed through advanced investigative techniques.
The Critical Viable vs. Non-Viable Spore Distinction
This is where the health implications of DIY kits become particularly concerning. Many DIY kits primarily focus on growing mold cultures, which means they can only detect viable (living) mold spores. However, both viable and non-viable (dead) mold spores can be equally harmful.
Dead mold spores still retain their mycotoxins and allergens, which can trigger allergies, asthma attacks, and other respiratory issues in sensitive individuals. For instance, toxic molds such as Stachybotrys chartarum (often called “black mold”), Ulocladium, and Chaetomium globosum can die and leave behind harmful residues that are undetectable by these petri dish plates. Yet, these residues can remain on surfaces and fabrics for months, continuing to cause health complaints.
The NIH has published research on household molds linked to health issues, highlighting the serious impact mold can have, even if it’s no longer actively growing. Relying on a kit that only detects active growth means you could be ignoring a significant health risk, especially for vulnerable family members in your home in Villanova, PA, or Old Bridge, NJ.
Ignoring the Root Cause: The Moisture Source
Mold doesn’t just appear out of thin air; it needs moisture to thrive. Whether it’s a persistent leak, high indoor humidity, or condensation, a moisture source is the fundamental problem that needs to be identified and addressed. This is arguably the most crucial step in any mold investigation.
DIY mold test kits completely fail to address this. They offer no tools or methodology to pinpoint the source of water intrusion. You might get a “positive” mold result, but you’re still left scratching your head, wondering why it’s there. Without identifying and fixing the moisture problem, any mold remediation efforts will be temporary. The mold will simply return.
For us at Stucco Safe, identifying the source of moisture is paramount. Our forensic testing methods and certified inspectors are trained to trace water intrusion, even when it’s hidden deep within wall cavities or behind stucco in places like Berwyn, PA, or Paoli, PA. We understand that mold is merely a symptom of a larger moisture problem. If you suspect hidden moisture or mold, understanding how to Check for Mold in Air is just one piece of the puzzle; finding the source is key.
Professional Mold Inspection: A Comprehensive & Accurate Alternative
When it comes to mold, accurate information is power. And that power doesn’t come from a DIY kit. Professional mold inspections offer a comprehensive and accurate alternative that goes far beyond simply detecting the presence of spores. We’re talking about a thorough, scientific approach designed to pinpoint the problem, understand its scope, and guide effective remediation.
Our Certified Microbial Investigators, for example, are equipped with specialized knowledge and tools that no homeowner kit can replicate. This includes controlled air sampling devices that precisely measure spores per cubic meter, advanced moisture meters to detect hidden dampness, and thermal imaging cameras that can reveal temperature differences indicative of moisture within walls without destructive testing. We also use forensic testing methods, like those we employ for stucco inspections, to get to the root cause of moisture intrusion.
This level of detail is essential for homeowners in areas like Philadelphia, PA, or Lakewood, NJ, especially when dealing with the complexities of older homes or specific building materials like stucco.
The Method: Beyond Just Sampling
A professional mold inspection is a multi-faceted process that considers your entire home environment. It’s not just about collecting a sample; it’s about understanding the whole story.
Here’s a comparison of what you get with a DIY kit versus a professional inspection:
| Feature | DIY Mold Test Kit | Professional Mold Inspection |
|---|---|---|
| Methodology | Settle plate (gravity-based), uncontrolled sampling. | Controlled air/surface sampling, visual inspection, moisture mapping, thermal imaging. |
| Accuracy | Low. Prone to false positives/negatives. Cannot quantify airborne levels. | High. Provides quantifiable data (spores/m³), compares to outdoor levels. |
| Scope | Limited to a small, open area. Cannot detect hidden mold. | Comprehensive. Inspects entire building envelope, including hidden areas like wall cavities and HVAC systems. |
| Outcome | A simple “positive” or “negative” result with no context or action plan. | A detailed report identifying mold types, concentrations, moisture source, and a clear remediation protocol. |